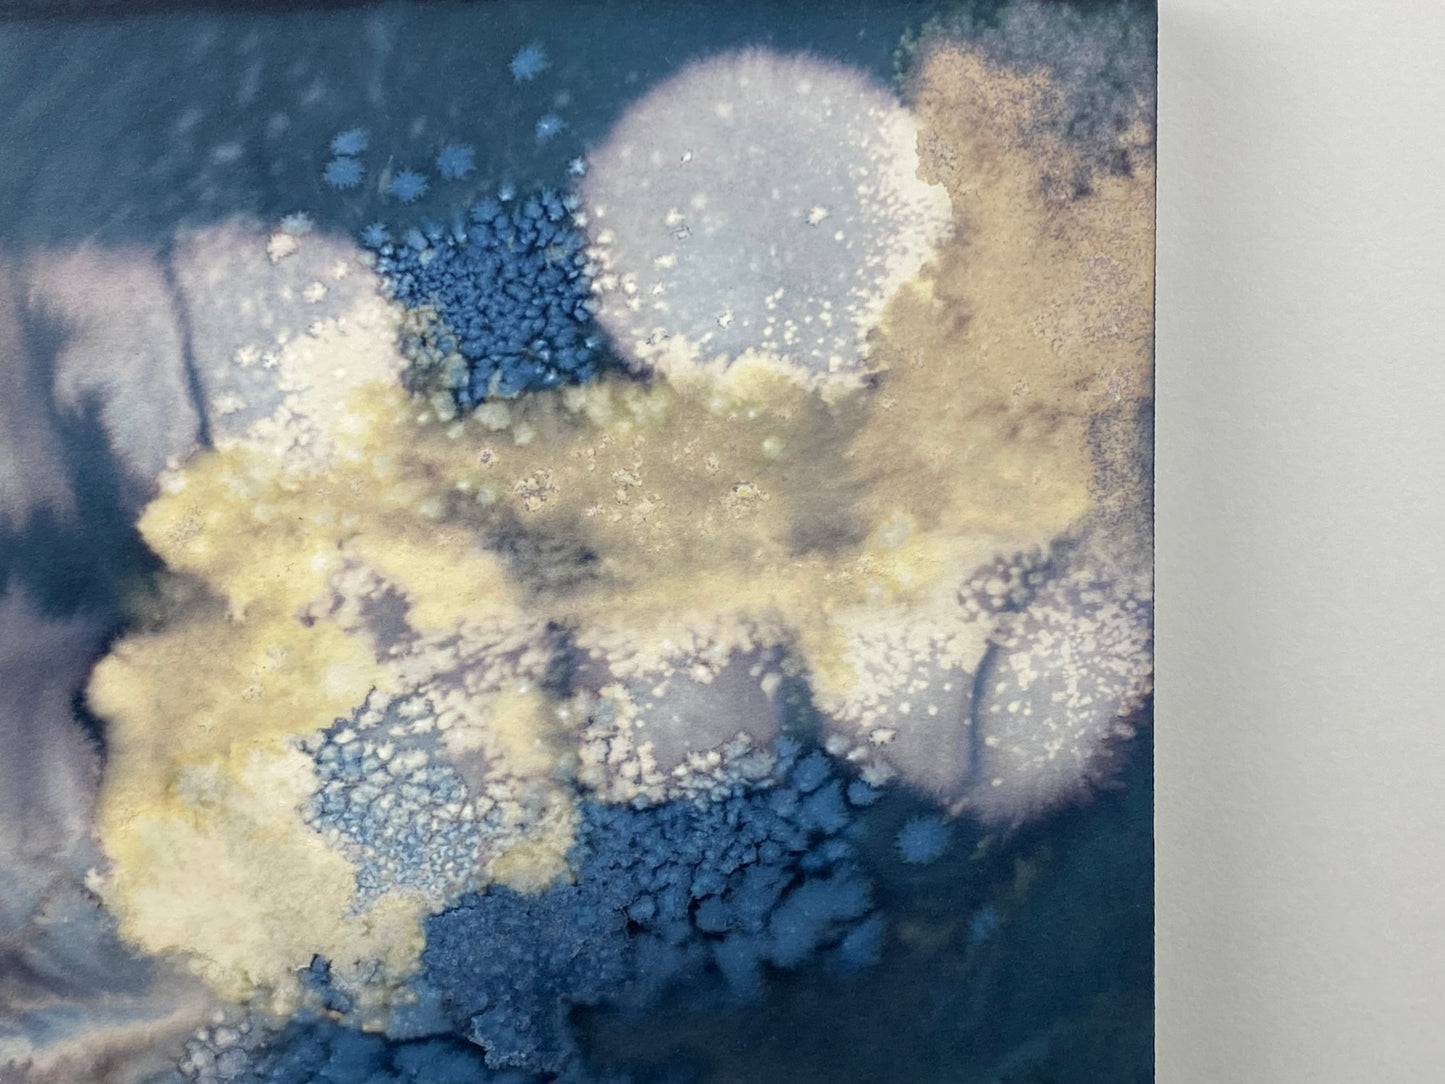
Original Cyanotype 8x8, Wall Art, Shelf Art

I'm very happy with the marbled papers I received. The colors were true to the pictures, and you can tell the paper used is high quality. I'm looking forward to using them in my bindings.
Just a fabulously beautiful and high quality handmade book. It is a true treasure. Thanks for sharing your talents.
The craftsmanship is outstanding, and the quality is top rate!
The leather is so soft; the binding, sturdy; the details, just gorgeous. Such thoughtful, exquisite craftsmanship. I've purchased several journals for friends -- refillable pocket-sized, sketchbooks, blank journals -- and they have loved them as much as I have. Really beautiful work. Think you'll love it too.
Each year, I get myself a Scroll & Ink Journal for Christmas that will hold my thoughts and experiences for the year ahead. This is the first time I’ve tried a buttonhole, but I like the look of it and can’t wait to crack it open!